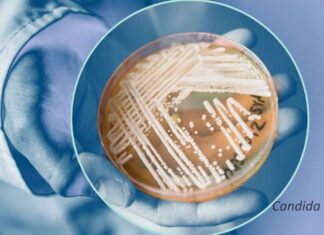
Funghi e Malattie

Home Homepage cibus
Homepage cibus
In tendenza
Prima pagina
Molino Grassi NEWS. Mercato cerealicolo condizionato dalle guerre.
Il conflitto medio orientale apre alla massima incertezza e volatilità.
A cura di redazione Molino Grassi Parma, 20 marzo 2026 - In queste ultime settimane...
Agricoltura e Lavoro
Dalle vigne al chiostro: il fascino senza tempo dell’Abbazia di Novacella
Di Mario Vacca Parma, 19 marzo 2026 - Tra le pieghe della Valle Isarco, dove le montagne sembrano custodire silenzi antichi e il vento...
“Cereali e dintorni”. Dopo le fermate, l’impennata.
Uno scenario bellico che fa saltare la quiete dei mercati.
Di Mario Boggini e Virgilio Milano, 19 marzo 2026 - Segnalazione del 12 marzo 2026...
Alimentazione
Politica agricola
Oggi SI Vota! NO Quorum!
Seggi aperti Domenica 22 marzo dalle 7 alle 23, mentre il lunedì dalle 7 alle 15. Non serve il quorum. Per votare bisogna presentarsi...
Agroalimentare
Economia
Parmigiano Reggiano protagonista ai Miami Open: è l’Official Cheese del torneo...
Dal 15 al 29 marzo, l’icona del Made in Italy rinnova la partnership con uno dei tornei di tennis più prestigiosi al mondo. Un...
Ambiente e sostenibilità
ADBPO cambio al vertice
Alessandro Delpiano nuovo Segretario Generale dell’Autorità di Bacino Distrettuale del fiume Po
Bolognese, 56 anni, ingegnere civile, già direttore dell’Area Pianificazione Territoriale della Città Metropolitana...
Francesca Mantelli eletta alla presidenza della Bonifica Parmense per il secondo mandato (Video)
Mantelli: “Ringrazio la lista che mi ha sostenuto a conferma dell’operato svolto. Nomina che mi inorgoglisce e responsabilizza ulteriormente per il futuro del territorio”
12...
Dalla sostenibilità dichiarata alla sostenibilità dimostrata: la fine del greenwashing come strategia comunicativa
Di Mario Vacca Parma, 3 febbraio 2026 - Con lo schema di decreto legislativo di attuazione della Direttiva (UE) 2024/825, l’ordinamento italiano compie un...
La Bonifica Parmense al voto per eleggere la governance 2026-2030
Si voterà domenica 14 dicembre 2025, dalle ore 9 alle ore 19, in 5 seggi di Parma e nelle 21 sedi dislocate nei comuni...
TG AMBIENTE del 23 marzo 2025 – Con “RiforestAzione” la natura torna protagonista in 13 città...
TG AMBIENTE del 30 marzo 2025 - Ue, un piano per case accessibili e sostenibili (Video)
ROMA (ITALPRESS) 30/03/2025, 15:00:00 - In questo numero del Tg Ambiente, prodotto dall'Italpress...
Funghi e Malattie
Scienze -
Le naturali difese immunitarie dei mammiferi contro le micosi non reggono all’impatto dei cambiamenti ambientali in corso.
Di Antonio Marsilio Modena, 11 marzo 2024 -...